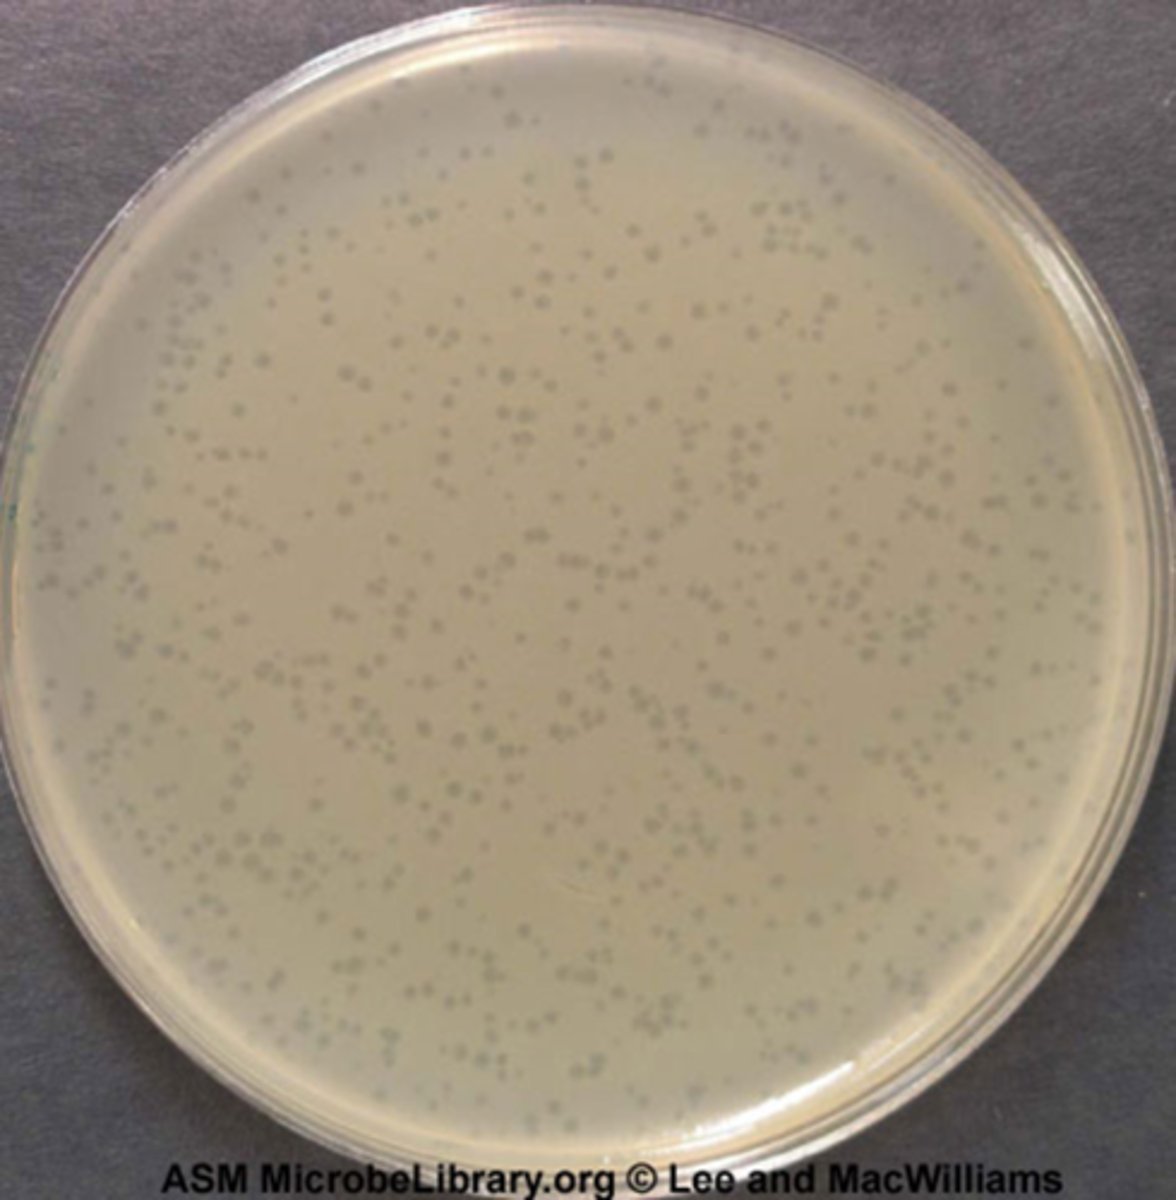
<p>Calculation Formula:</p><p>1. count the number of colonies you see</p><p>2. multiply by given number in dilution series (add that many zeros)</p><p>3. move the decimal over until you reach the end of the number</p><p>4. record number with positive exponent in CFU/mL</p><p>ex: 6.8 x 10^9 CFU/mL</p>
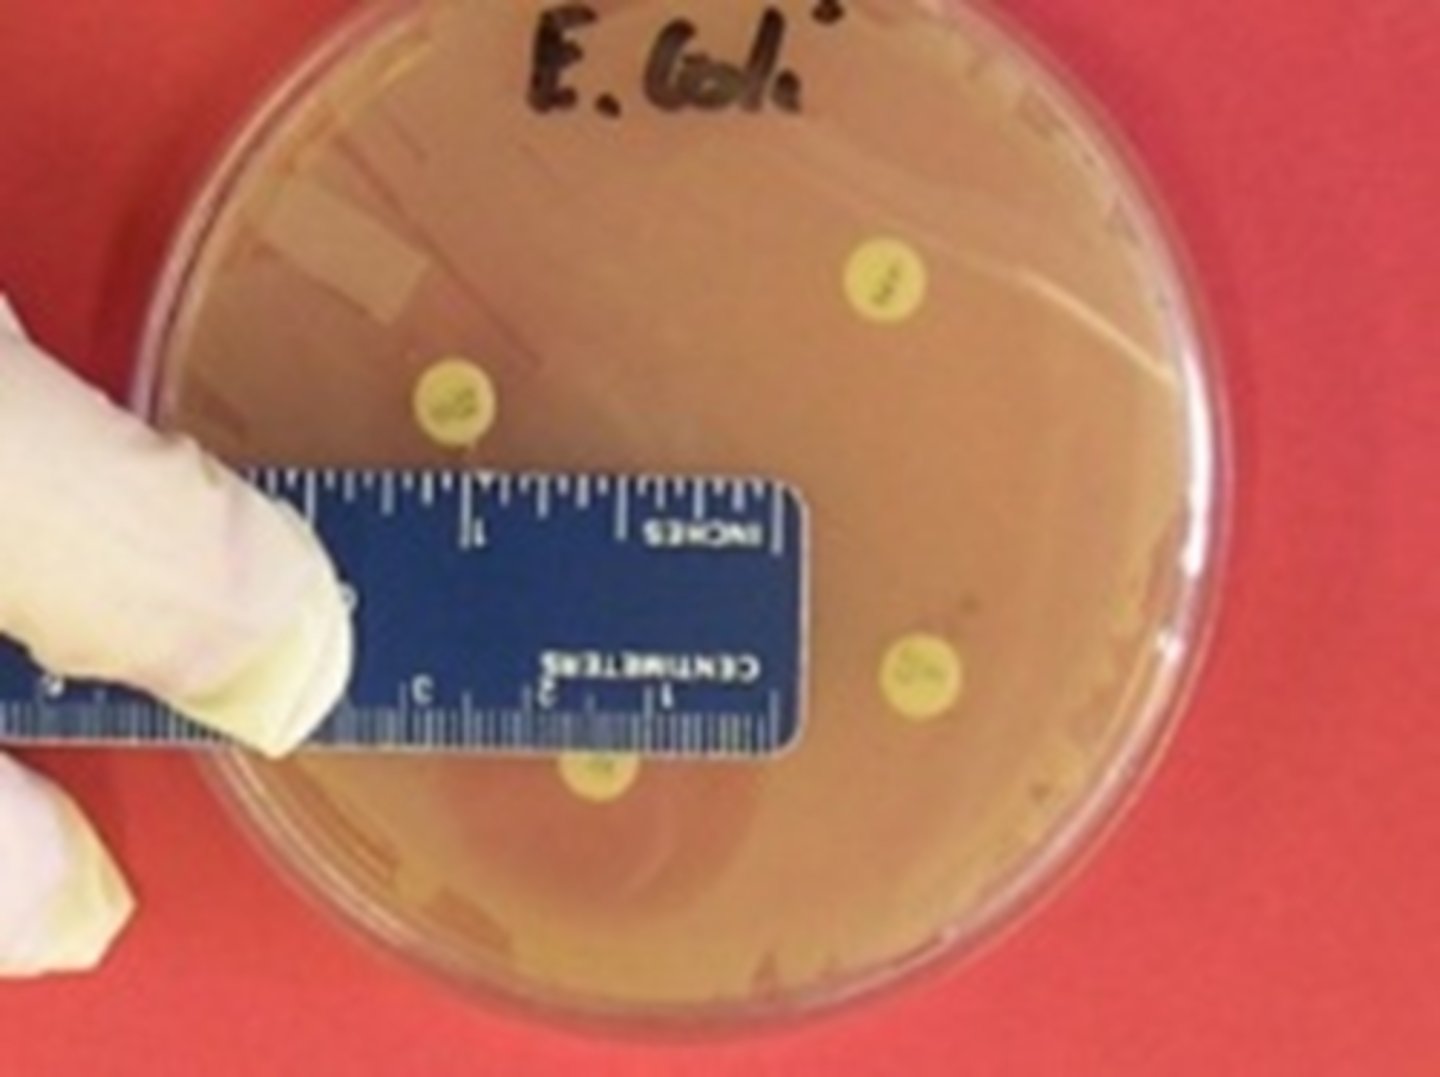
knowt flashcard image
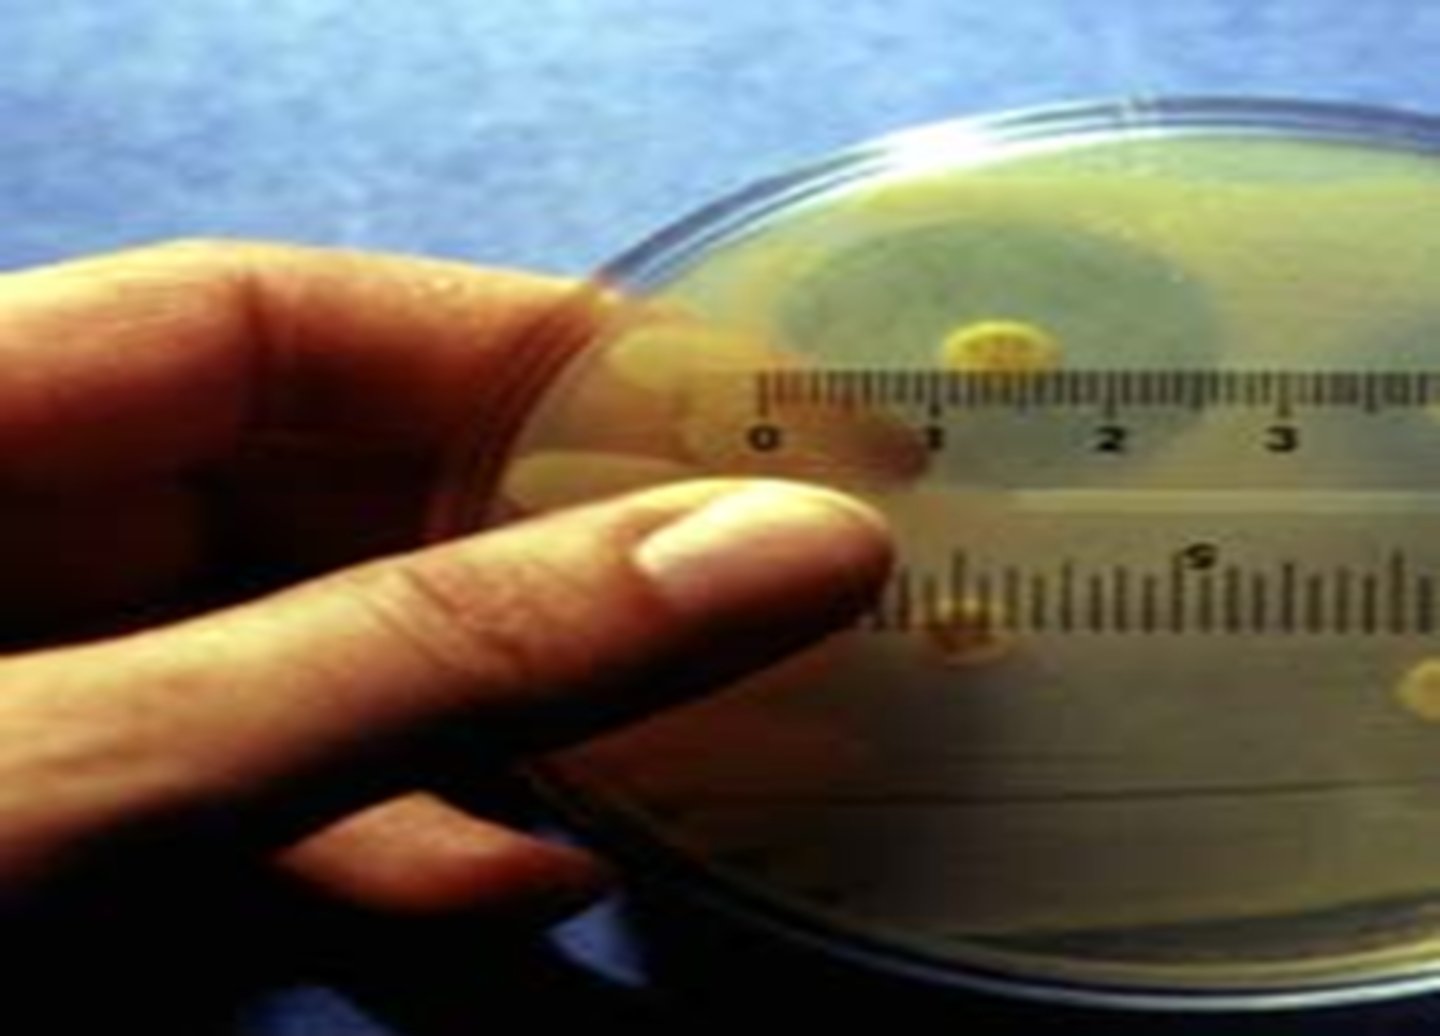
knowt flashcard image

1/114
Looks like no tags are added yet.
Name | Mastery | Learn | Test | Matching | Spaced | Call with Kai |
|---|
No analytics yet
Send a link to your students to track their progress
What are the 3 possible bacteria shapes?
spirilla (cork-screws)
cocci (spheres)
bacilli (rods)

List the three bacterial shapes you observed on the prepared slide, using the correct terminology
While observing the mixed bacteria slide, I found three different bacteria shapes. The first bacterium that I observed was the coccus. The multiple cocci that I found were spherical shaped. The second bacterium that I found was the bacillus. The many different bacilli that I observed had rod-type shapes and had different lengths. The last bacterium that I observed was the spirillum. The different spirilla I located had spiral shapes.
What is the total magnification when you observe a bacteria with the "Oil Immersion" objective of your microscope?
1000x.
What does "parfocal" mean?
Most microscopes are parfocal, meaning that when one lens is in focus, all the other lenses will be in focus with only minor adjustment of the fine focus
What is function of the coarse adjustment -vs-fine adjustment knobs?
- The course adjustment knob may only be used at the scanning, or 4x, objective lens.
- The fine focus adjustment knob is used at the other levels of magnification to enhance the focus of the specimen under the microscope from the initial focus point.
- Both: In order to focus on the specimen, the stage is raised and lowered with either the course adjustment or fine focus knobs located on the arm
What is the function of the iris diaphragm?
The iris diaphragm is an adjustable opening that controls the amount of light that enters that exits the condenser and enters the sample
What is the function of the condenser?
The condenser is located directly under the stage; it contains several sets of lenses that concentrate the light from the light source on to the specimen
What is true motility?
purposeful & directional swimming movement
What is Brownian motility?
the erratic vibration of a particle caused by the unequal collision of water molecules against it
What is streaming motility?
where all the objects “flow” with the movement of the water
How are bacterial names written?
- genus (capital) then species (lowercase)
- italicized/underlined
What is the correct way to store your microscope?

What is the function of immersion oil?
This oil has the same refractive index as glass, meaning that the light will not scatter before it enters the objective lens. This produces a clearer, sharper image than would be possible otherwise.
What type of microscope was used in class?
compound brightfield microscope
What are the magnification levels of this microscope?
4X (scanning)
10X (low power)
40 X (high-dry)
100X (oil immersion)
(ocular usually has a magnification of 10X)
What are the 3 types of cell arrangements?
strepto- (line)
staphylo - (clump)
diplo - (2 next to each other)
What is the purpose of heat-fixing a slide before staining?
This heat-fix step "fixes" the cells to the slide i.e., attaches them to the slide and preserves their original shape and arrangement, and keeps them from being washed away during staining.
Immediately following the ethanol decolorization step, how would a:
Gram-positive bacterium appear under the microscope?
Gram-negative bacterium appear under the microscope?
- Gram-positive cells stained purple
- Gram-negative cells are colorless
Why must the loop be flamed and cooled before use, AND flamed immediately after use?
The loop must be flamed and cooled before use to disinfect the instrument from putting unwanted bacteria into the culture. The loop is also flamed after use to make sure it is completely disinfected before doing anything else with it or carrying unwanted bacteria. These measures make it so the laboratory room is sterile and avoid the spreading of bacteria
What are the structural differences between Gram Positive and Gram Negative bacteria?
- Gram-positive bacteria have a thick cell wall that contains peptidoglycan and teichoic acid, and does not easily decolorize.
- Gram-negative bacteria have a thin layer of only peptidoglycan in their cell wall, which is quickly decolorized. (Gram-negatives also have an LPS layer).
What is the most important step of a differential stain? Why? Do simple stains have this step?
- ethanol rinsing
How can you tell if a Gram stain is positive or negative?
pink = negative
purple = positive
What is the procedure for Gram staining?
1. Place ONE slide on one of the slide holders (bacteria side up) over the center sink. You can use a clamp, or not, it is your choice! Flood the slide with crystal violet (the primary stain). Leave stain on for 1 minute.
2. Allow water to flow across the slide until it runs clear (about 10 seconds). Do not allow the stream of water to directly hit the smear.
3. Cover the smear with Gram's iodine (the mordant), and leave it on for 1 minute.
4. Allow water to flow across the slide until it runs clear (about 10 seconds). Do not allow the stream of water to directly hit the smear.
5. Decolorize the smear by letting 95% ethanol (decolorizing agent) flow across it for about 10 seconds.
6. Gently wash the smear with water for about 10 seconds.
7. Cover the smear with safranin (the counter stain), and leave it on for 1 minute.
8. Gently wash the smear with water for about 10 seconds, or until it runs clear. Place the slide IN the bibulous paper pad, close the pad, and blot the slide gently to dry it (press, don't rub). Drip some 95% ethanol on a kimwipe and wipe the back of the slide off. CAUTION! Be sure you are wiping off the stain on ONLY the BACK of the slide!
Describe this Gram stain.
- cocci (spheres)
- purple = positive
- arrangement: streptococci, diplococci, staphylococci

Describe this Gram stain.
- bacilli (rods)
- pink = negative
- arrangement: streptobacilli, staphylobacilli, diplobacilli

Describe this Gram stain.
- spirilla (spirals)
- purple = positive
- arrangement: streptospirilla, staphylospirilla, diplospirilla

Name the mordant in the Acid fast and Endospore stains.
heat
Why do endospores require harsh treatment to be stained or killed?
Bacterial endospores are very hard to pass through. They are also very thick, which contributes to the fact that they use harsher treatments to allow entry. During lab, we must use a strong force, like heat and fire, to be able to pass this barrier and incorporate the stain into the endospore. The same principles can be applied to killing them. Since endospores are so strong, it is not easy to kill them without using these same extreme measures.
Name a Genus of Bacteria that forms endospores. What color is the endospore andthe rest of the bacteria after an endospore stain?
Endospores are only found in Gram-positive bacteria, primarily within the genera Bacillus and Clostridum.
After using an endospore stain, the endospores become green and the bacteria become red.
Mycolic acid is found in what Genus of bacteria? How will this bacteria stain in an Acid-Fast stain? Name a disease caused by Acid Fast bacteria.
- Two important genera that have mycolic acid in their cell walls are Mycobacterium and Nocardia. These two genera include several important pathogenic (disease-causing) organisms, making the acid-fast stain a valuable diagnostic tool. Some of the diseases caused by Mycobacterium species include tuberculosis and leprosy, while Nocardia cause certain skin infections.
- Bacterial cells that do not decolorize, and therefore remain red after the procedure, are called “acid-fast”. Their cells walls contain a waxy lipid called mycolic acid, which retains the carbolfuchsin stain.
What are bacterial capsules?
Bacterial capsules are polysaccharide-containing layers outside the bacterial cell. They can increase a bacterium's virulence (ability to cause disease), survival of desiccation, and attachment to surfaces.
Name a reason why capsules are helpful to bacteria. Why are capsule-forming bacteria dangerous to humans?
Capsules are helpful to bacteria for several different reasons. One example being that they allow bacteria to live through being completely dried out. This increases the lifespan of the bacteria and allows them to survive in harsher conditions. Another example is that capsules increase the ability bacteria possess to adhere onto different locations. This allows the bacteria to spread without being killed, since they can attach more strongly with the use of a capsule. Capsule-forming bacteria are dangerous to humans because of their tendency to bring about illnesses, which could cause humans to catch a disease and get sick. They also have an extreme ability to survive, which makes them hard to get rid of once caught.
What color do acid-fast cells stain? Non-acid fast?
acid-fast = red
non acid-fast = blue
Describe this acid-fast slide.
- stained red = acid-fast cells

Describe this acid-fast slide.
- stained blue = non acid-fast

What are the stains used in the acid-fast procedure?
- primary stain contains carbolfuchsin dye (which is red) in a 5% phenol solution, and the slide + stain is heated
- decolorization step uses acid alcohol
- counter stain is methylene blue
- bacterial cells that do not decolorize, and therefore remain red after the procedure, are called "acid-fast". Their cell walls contain a waxy lipid called mycolic acid, which retains the carbolfuchsin stain.
- cells that did decolorize are counterstained with methylene blue to allow their visualization.
- Acid-fast cells therefore stain red whereas non-acid-fast cells stain blue in color
What are bacterial endospores?
- resting bodies formed by certain bacteria in response to harsh conditions
- allow the bacteria to survive until growth conditions are more favorable, but do not represent reproductive structures
- only found in Gram positive bacteria
- dense and impermeable
Capsule Slide.
- capsule is the clear area in between the stained cell and the stained background
- best way to visualize capsules is by combining a negative stain and a positive stain

Endospore Slide.
- Schaeffer-Fulton procedure: uses malachite green to stain the endospores and safranin as counterstain
- Heat applied, to drive the primary stain into it endospore. (If it is not heated, the stain won’t work!)
- Once stained, the endospore will also not decolorize easily.
- Therefore, decolorization followed by counterstaining yields green endospores and red bacteria

Both of your nutrient broth tubes should have growth. If you had forgotten to label which tube is which, could you tell what culture is in each tube? Why or Why Not? (ie: If your neighbor vortexed your tubes by mistake, could you tell which tube contains the pure culture and which one contains the mixed culture?)
No, I could not have told the difference between the pure and mixed cultures by looking at the nutrient broth tubes. When putting the cultures into the tubes, they do not have the freedom to differentiate as much as when they are put onto an agar plate. After incubation, my nutrient broth tubes looked the same - they were cloudy, and had a bacterial ring at the top of them.
All of the media you use in class is sterilized before you inoculate it. How can you tell the media is sterile with:
*Nutrient broth tubes?
Nutrient broth tubes are sterile if they appear clear. Cloudiness/turbidness means they are not sterile.
All of the media you use in class is sterilized before you inoculate it. How can you tell the media is sterile with:
*Nutrient agar plates?
there would be no growth on plates of any kind or color
The streak plate, the pour plate and the spread plate all produce isolated colonies, using different methods. How are the methods different?
The methods of the streak, pour, and spread plates have several key differences. One main difference of the three is that they use different tools to isolate colonies. The streak plate uses a sterile loop, the pour plate does not use an instrument, and the spread plate uses a bent rod of glass. They are also spread out differently. The spread plate is spread over a plate, the streak plate is spread across a solid medium, and the pour plate is poured into a petri dish.
What is a colony, and how does it form?
Alternatively, a single, isolated cell on a solid surface may multiply until it forms a colony, which is a visible mound of millions of its descendants, all arising from one cell.
How are plaques formed by bacteriophage?
Plaques are formed when the bacterial cells are swelled up by the addition of the bacteriophage. This forms an opening, or a plaque, where a singular piece of the virus was able to maturate into a new community (population). Once the virus is inside a bacteria cell, it takes control of the cell and uses it to reproduce many more virus which in turn lyse the bacteria cell, which causes the empty zones (the plaques)
In a TCC stab, how can you tell if motility is positive or negative?
fuzzy edges = positive for motility
non-fuzzy edges = negative for motility
Bacteriophage plate
Calculation Formula:
1. count the number of colonies you see
2. multiply by given number in dilution series (add that many zeros)
3. move the decimal over until you reach the end of the number
4. record number with positive exponent in CFU/mL
ex: 6.8 x 10^9 CFU/mL
TCC stab with positive motility

TCC stab with negative motility

Why can Iodine be used to detect the presence/location of starch in the starch agarplates?
- Starch is a large polymer made up of glucose subunits; one of its unique properties is forming a very dark chemical, complex with iodine… The iodine combines with starch to give a brown to black color.
- The location of the dark complex formed is the location of the starch in the starch agar plates.
None of the five known cultures is an obligate anaerobe. Why can't one of your known cultures be an obligate anaerobe?
None of the known cultures can be an obligate anaerobe because this type of bacteria are killed when they are exposed to oxygen. This means that they would not have been able to survive the experiment when the culture was being added. Taking the cap off of the tube to add the culture would expose the bacteria to oxygen, therefore causing them to be killed.
What two compounds are produced by the action of urease on urea? Which one raises the pH of the medium?
The two compounds that are produced by the action of urease on urea are ammonia and carbon dioxide. Of the two, the compound that raises the pH of the medium is ammonia.
What two general products are potentially formed by the fermentation of sugars? How are the two products visualized in the tube (How can you see them)?
- The two general products that are potentially formed by the fermentation of sugars are acids and gases.
- These products are visualized by color changes and the appearance or nonappearance of gas bubbles.
- The pH indicator, phenol red, is red above pH 7 and yellow below. A yellow tube thus indicates production of organic acid from the carbohydrate, i.e. fermentation. The presence of a bubble in the inverted tube indicates production of gas (hydrogen and carbon dioxide) from the carbohydrate. Red and no bubble is negative for both acid and gas.
What did the KOH test tell you about the cell wall/Gram Reaction of your bacteria?Does this information match with your Gram stain results?
The KOH test that I performed had a positive result, where the liquid thickened and became stringy. This told me that my bacteria was gram negative, because the result produced by the KOH test is the opposite of the Gram result. This information does match with my Gram stain results because I observed pink bacilli, which is a negative Gram result. A cell that is Gram negative has a thin cell wall that is made of only peptidoglycan. This cell wall is easily decolorized.
How is the catalase test performed?
1. Transfer a large amount of growth from NA slant to slide
2. Place a large drop of hydrogen peroxide on bacteria
3. Observe for bubbles
What does a positive catalase result in?
- produces many bubbles
- indicates oxygen release

What does a negative catalase test result in?
no bubbles

How is a citrate test performed?
- Aseptically inoculate a citrate agar slant using stab and streak method
What does a positive citrate test result in?
any part of agar turns blue

What does a negative citrate test result in?
remains green

How is hydrogen sulfide production (H2S) tested?
- Aseptically inoculate using the stab method into the SIM tube
What does a positive hydrogen sulfide test result in?
More than 50% of tube is black

What does a negative hydrogen sulfide test result in?
Small amount of black or no black

How is a KOH test performed?
1) scrape bacteria off of NA slant onto slide
2) add 5% KOH and observe
What does a positive KOH test result in?
liquid thickens, becomes stringy

What does a negative KOH test result in?
no change in liquid

What does a negative KOH test indicate? Vice versa?
negative KOH = Gram positive bacteria
positive KOH = Gram negative bacteria
How is an indole test performed?
add a full dropper of Kovac's reagent to the SIM tube after performing the H2S test
What does a positive indole test result in?
red layer formed on top

What does a negative indole test result in?
yellow/green layer formed on top

How are tests for glucose/dextrose, sucrose, and lactose formation performed?
Aseptically use your loop to inoculate a tube that contains phenol red and a Durham tube to test for acid and gas
What does an acid positive test result in?
tube turns yellow
What does an acid negative test result in?
tube remains pink/red
What does a positive gas test result in?
formation of a gas bubble
What does a negative gas test result in?
no gas bubble formed
What would be the results of this test tube?
- negative acid (pink)
- negative gas (no bubble)

What would be the results of this test tube?
- positive acid (yellow)
- negative gas (no bubble)

What would be the results of this test tube?
- positive acid (yellow)
- positive gas (bubble formed)

How is starch hydrolysis tested?
Add bacteria to starch agar plate, let incubate, add special Gram's iodine to plate and wait 5 min.
What does a positive starch hydrolysis test result in?
Produces amylase - halo, orange yellow color, clearing formed

What does a negative starch hydrolysis test result in?
Does not produce amylase - dark even under growth

How is urea production tested?
aseptically inoculate urea broth tube by using your loop to add bacteria
What does a positive urea test result in?
tube turns hot pink

What does a negative urea test result in?
tube remains yellow/peachy color

How is the oxygen requirement tested?
aseptically inoculate the THIO tube by using your needle
What does an obligate aerobe result in?
Growth just at top and small blue layer

What does a facultative anaerobe result in?
Growth throughout whole tube, heavier, blue layer still present

Why is it important to use good aseptic technique during your inoculations, especially when doing unknown identifications?
It is important to use good aseptic techniques during your inoculations to prevent the pure culture, that is being tested, from mixing with any external environmental factors. If any factors mix with the pure culture, it could contaminate the bacteria. This could change the way bacteria responds to a certain test and give incorrect results. This is especially important when identifying unknown bacteria, since the results need to be as accurate as possible to correctly name the bacteria you are experimenting with.
What is the difference between a bacteriostatic treatment and a bactericidal treatment?
The difference between a bacteriostatic treatment and a bactericidal treatment is that a bactericidal treatment exerts its effect by permanently killing the bacteria. On the other hand, a bacteriostatic treatment only inhibits growth for a nonpermanent period of time before it resumes.
Was the test compound Lysol more toxic than phenol? Why do you think this way?
According to my observations, I concluded that Lysol is more toxic than phenol. I think this way because phenol presented growth for all periods of time. Lysol, conversely, only showed growth at 0, 2.5, and 5 minutes. After 5, minutes the Lysol appeared to have killed all remaining bacteria. This presented as negative growth during the 10- and 20-minute periods.
Can the agar diffusion method be used to accurately determine the dosage of drug to be consumed internally by a patient? Explain your answer.
No, the agar plate diffusion method cannot be used to accurately determine the dosage of a drug to be consumed internally by a patient. The agar diffusion method was used to test how well antibiotics protected against specific bacteria and bacteria species. Therefore, since this method is a test for the effectiveness of an antibiotic, it would not be used to determine the dosage of an antibiotic. It also does not take into account other important factors that contribute to dosage (weight, height, allergies, etc)
Why can an antibiotic be swallowed or injected, but not a disinfectant?
Antibiotics can be swallowed or injected because they are compounds that are safe for our internal environment to absorb/ingest. The goal of antibiotics is to fight off living bacteria inside our bodies and to get rid of anything causing illness. Alternately, disinfectants are chemicals that are not meant to be used on living things and organisms, but on lifeless objects. Disinfectants are not meant to be ingested or swallowed by living organisms, like humans; they are often used on inanimate objects for cleaning. Because in addition to killing the bacteria, a disinfectant will damage our cells as well if ingested
Why would it be important to know the identity of the pathogen before treating an infection with an antibiotic?
It would be important to know the identity of the pathogen before treating an infection with an antibiotic so that you make sure to know which antibiotic needs to be used. If you do not know the identity of the pathogen, it is difficult to know what antibiotic will need to be used against a pathogen to be effective and exhibit positive results against it. Identifying the pathogen first will provide the quickest, most effective treatment plan when selecting which antibiotic to use. Quickest treatment plan is to prescribe a broad-spectrum antibiotic that is effective against a wide range of microbes but it is beneficial to know the bacteria as then you can potentially choose a drug that is narrow spectrum and will kill the pathogen without killing your normal flora, the good bacteria.
What is one method used to test the effectiveness of antibiotics?
1. Tube Dilution
- consists of a serial dilution of the antibiotic, to which a standard amount of bacteria is added to each tube
- After incubation, the highest dilution of antibiotic with no growth is the minimum inhibitory concentration (MIC).
- MIC is the exact value of the smallest amount of antibiotic that kills/inhibits the MOs.
Lysol Tube Dilution

Phenol Tube Dilution

What is another method used to test the effectiveness of antibiotics?
1. Kirby-Bauer agar diffusion method
- A micro-organism is first spread over the surface of a petri plate.
- Paper discs impregnated with various antibiotics are then placed on the surface of the agar.
- During incubation, the antibiotic diffuses from the disk, forming a concentration gradient in the plate itself: high concentration near the disk and decreasing concentration out into the surrounding area.
- If the antibiotic inhibits the organism, a clear zone of inhibition (area of no growth) will appear around the disk as a confluent lawn of cells develops everywhere else on the plate.
- The size of this zone roughly indicates the effectiveness of that antibiotic against that bacterial species since zone size can also be affected by many different factors, including the rate of diffusion, the size of the inoculum, the growth stage of the bacteria...
- The diameters of the zones of inhibition are measured and compared to a standard chart to determine if this bacteria is sensitive, intermediate, or resistant to an antibiotic
Kirby Bauer Plate 1 (know unit)
Kirby-Bauer Plate 2

Kirby-Bauer Plate 3